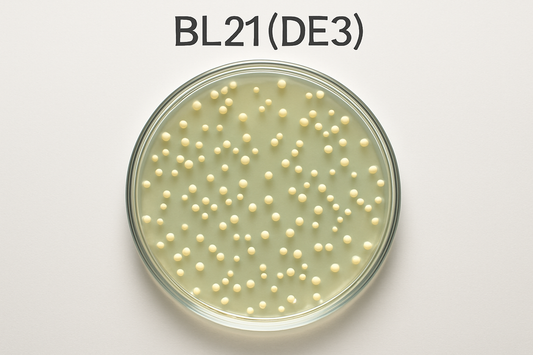
Whole Genome Sequencing of BL21(DE3)

Posts

How I used Google Colab’s A100 to basecall 100 ...
After encountering corrupted FASTQ files during live basecalling on Oxford Nanopore’s MinION, the we share an alternative to slow post-run basecalling on modest GPUs. Instead of buying an expensive Nvidia...
How I used Google Colab’s A100 to basecall 100 ...
After encountering corrupted FASTQ files during live basecalling on Oxford Nanopore’s MinION, the we share an alternative to slow post-run basecalling on modest GPUs. Instead of buying an expensive Nvidia...

Amplicon Sequencing Using to Validate a Locus
The SS3 locus is a commonly used integration locus in E. coli engineering (Bassalo 2016). Here we validate the wildtype locus (containing the gRNA target sequence) using primers Primer...
Amplicon Sequencing Using to Validate a Locus
The SS3 locus is a commonly used integration locus in E. coli engineering (Bassalo 2016). Here we validate the wildtype locus (containing the gRNA target sequence) using primers Primer...
Whole Genome Sequencing of BL21(DE3)
The example below shows the Bacterial whole genome sequencing result for BL21(DE3), a host frequently used for T7 promoter expression. For the analysis below, the updated 2024 reference sequence NZ_CP053602.1 was...
Whole Genome Sequencing of BL21(DE3)
The example below shows the Bacterial whole genome sequencing result for BL21(DE3), a host frequently used for T7 promoter expression. For the analysis below, the updated 2024 reference sequence NZ_CP053602.1 was...

Whole Plasmid Sequencing Example of pUC19
In the results portal, you will find a Whole Plasmid Sequencing output for the famous cloning vector pUC19. https://seqresults.angstrominno.com/orders/AI-1123 Name: pUC stands for plasmid University of California, referencing where it...
Whole Plasmid Sequencing Example of pUC19
In the results portal, you will find a Whole Plasmid Sequencing output for the famous cloning vector pUC19. https://seqresults.angstrominno.com/orders/AI-1123 Name: pUC stands for plasmid University of California, referencing where it...

Importance of Whole Plasmid Sequencing
Why Whole Plasmid Sequencing Beats SangerPlasmids mutate anywhere, anytime. Traditional Sanger sequencing only checks small regions, missing potentially critical mutations in origins, selection markers, or regulatory elements. In our latest...
Importance of Whole Plasmid Sequencing
Why Whole Plasmid Sequencing Beats SangerPlasmids mutate anywhere, anytime. Traditional Sanger sequencing only checks small regions, missing potentially critical mutations in origins, selection markers, or regulatory elements. In our latest...
